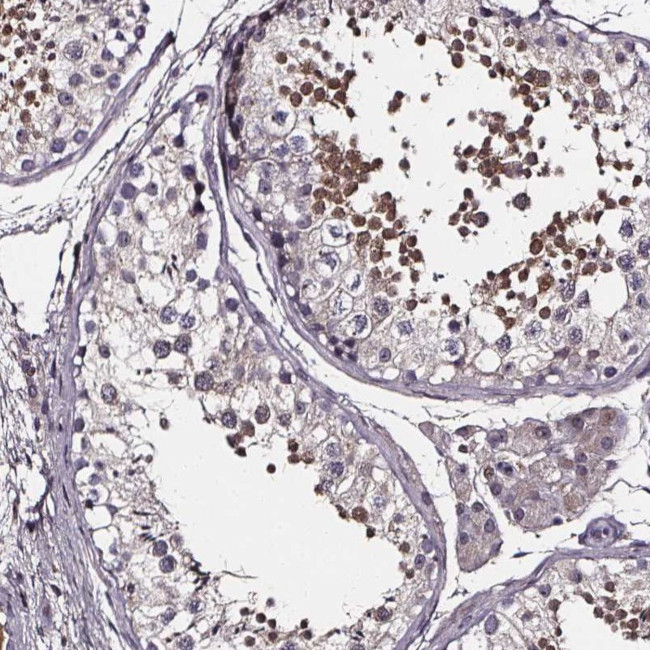
SPAG8 Antibody in Immunohistochemistry (Paraffin) (IHC (P))

Search
Invitrogen
SPAG8 Polyclonal Antibody
{{$productOrderCtrl.translations['antibody.pdp.commerceCard.promotion.promotions']}}
{{$productOrderCtrl.translations['antibody.pdp.commerceCard.promotion.viewpromo']}}
{{$productOrderCtrl.translations['antibody.pdp.commerceCard.promotion.promocode']}}: {{promo.promoCode}} {{promo.promoTitle}} {{promo.promoDescription}}. {{$productOrderCtrl.translations['antibody.pdp.commerceCard.promotion.learnmore']}}




Please note: We are reviewing Western blot images included in the antibody testing data in our catalog, including those provided by third parties. Unless expressly labeled or annotated as “raw-unedited”, Western blot images included in the antibody testing data in our catalog may have been edited, optimized or otherwise adjusted for presentation.
产品信息
PA5-64354
种属反应
宿主/亚型
分类
类型
抗原
偶联物
形式
浓度
规格
纯化类型
保存液
内含物
保存条件
运输条件
RRID
产品详细信息
Immunogen sequence: PGSGPGHGSG SHPGPASGPG PDTGPDSELS PCIPPGFRNL VADRVPNYTS WSQHCPWEPQ KQPPWEFLQV LEPGARGLWK P
Highest antigen sequence identity to the following orthologs: Mouse - 48%, Rat - 34%.
靶标信息
The correlation of anti-sperm antibodies with cases of unexplained infertility implicates a role for these antibodies in blocking fertilization. Improved diagnosis and treatment of immunologic infertility, as well as identification of proteins for targeted contraception, are dependent on the identification and characterization of relevant sperm antigens. The protein encoded by this gene is recognized by sperm agglutinating antibodies from an infertile woman. This protein is localized in germ cells of the testis at all stages of spermatogenesis and is localized to the acrosomal region of mature spermatozoa. Alternatively spliced variants that encode different protein isoforms have been described but the full-length sequences of only two have been determined.
仅用于科研。不用于诊断过程。未经明确授权不得转售。
篇参考文献 (0)
生物信息学
蛋白别名: HSD-1; SMP-1; Sperm membrane protein 1; Sperm membrane protein BS-84; Sperm-associated antigen 8
基因别名: SPAG8
Entrez Gene ID: (Human) 26206